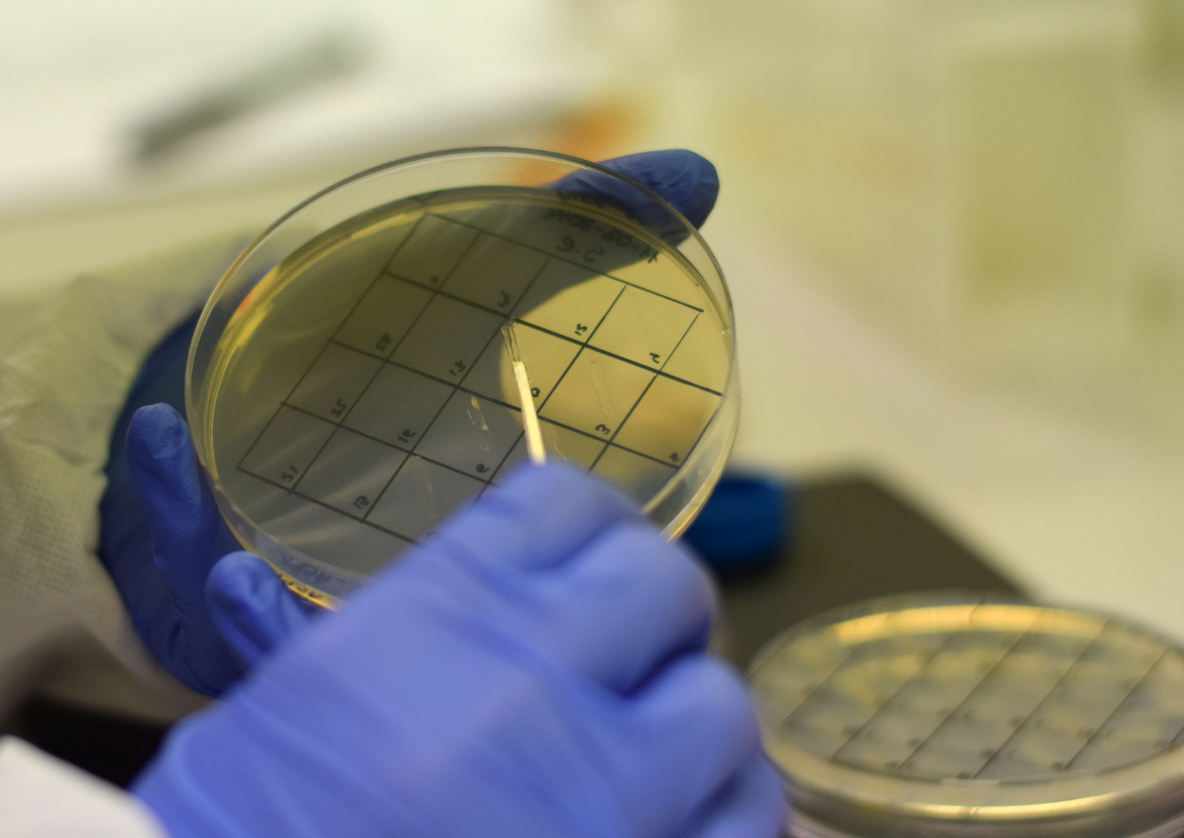

El proyecto MicroMundo, referente en ciencia ciudadana y aprendizaje-servicio, culmina su edición 2026 con una jornada de clausura en Salamanca que combina divulgación, resultados científicos y participación estudiantil. El encuentro, abierto al público, pondrá en valor el trabajo de los jóvenes en la búsqueda de nuevos antibióticos y abordará el reto de la resistencia antimicrobiana a través de una charla especializada, además de la presentación de resultados y la entrega de diplomas.
Esta iniciativa, que forma parte de redes internacionales de investigación educativa, acerca el método científico a jóvenes estudiantes mediante experiencias prácticas en microbiología. A través de una metodología participativa basada en el “crowdsourcing”, los alumnos colaboran activamente en la búsqueda de microorganismos con potencial antibiótico, replicando en cierto modo descubrimientos históricos como el de la penicilina.
Coordinado en España por la Sociedad Española de Microbiología (SEM), el proyecto cuenta con la implicación de cerca de una treintena de universidades, incluyendo la de Salamanca y centros de investigación distribuidos por toda la Península ibérica. Esta red permite que estudiantes de secundaria trabajen junto a investigadores, fortaleciendo el vínculo entre educación y ciencia de vanguardia. En Radio USAL, en el programa “Docencia con compromiso social”, presentamos a 5 alumnos del Grado en Biología (3º/4º) que están realizando el proyecto MicroMundo en distintos centros educativos de Salamanca este curso.

Además de su impacto en la investigación, MicroMundo tiene una clara vocación educativa: despertar vocaciones científicas en disciplinas STEM y promover una cultura científica más sólida entre la juventud. La iniciativa también contribuye a que los participantes comprendan la relevancia de la investigación biomédica en la vida cotidiana.
Con el creciente interés por parte de centros educativos, el proyecto continúa ampliando su alcance e invita a nuevos institutos a sumarse a esta red colaborativa que combina educación, investigación e innovación.
MicroMundo se presenta así como un ejemplo destacado de cómo la ciencia puede salir de los laboratorios para integrarse en las aulas y en la sociedad, generando impacto tanto educativo como científico.


